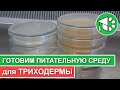

ПАПОРОТНИКИ КАК ПИЩА
Папоротники являются уникальными растениями, а некоторые виды из них также могут быть использованы в пищевой промышленности.
Хотя большинство папоротников не рассматриваются как основной источник пищи, но некоторые из них используются в кулинарии в определенных культурах. Например, молодые побеги некоторых видов папоротников могут быть съедены и часто используются в азиатской кухне.
Папоротники варятся или жарятся перед употреблением, что помогает устранить потенциально вредные вещества. Однако важно употреблять только те виды папоротников, которые безопасны для потребления. При приготовлении пищи из папоротников необходимо обратить особое внимание на процесс готовки и использовать только специальные сорта, рекомендованные для пищевого использования.
В целом, папоротники как пищевой продукт могут предоставить разнообразие и интересные вкусовые ощущения в кулинарии, но перед употреблением необходимо быть уверенным в безопасности конкретного вида и правильном приготовлении.
Папоротники - обзор, уход (август 2022 года)
Мобилизация и война на Украине - когда это кончится ? 10 шокирующих пророчеств о будущем России
В чем польза папоротника
Розеточные папоротники.
Папоротники - Советы от Ильи Гомыранова
ТРАВА КОТОРАЯ ЛЕЧИТ 80% болезней! Секретные свойства папоротника